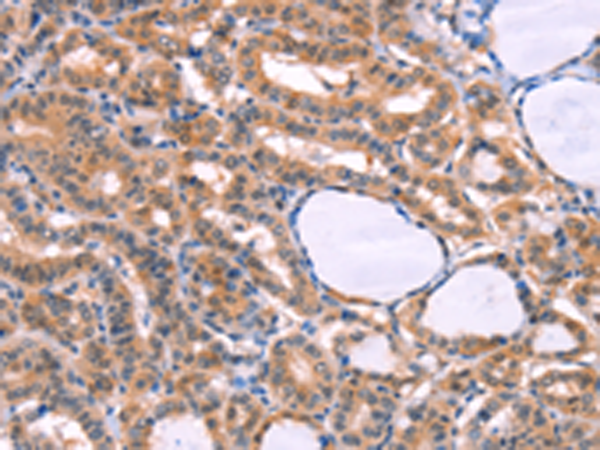

|
Background: |
This gene encodes a member of the cytochrome P450 superfamily of enzymes. The cytochrome P450 proteins are monooxygenases which catalyze many reactions involved in drug metabolism and synthesis of cholesterol, steroids and other lipids. The enzyme encoded by this gene localizes to the endoplasmic reticulum and metabolizes procarcinogens such as polycyclic aromatic hydrocarbons and 17beta-estradiol. Mutations in this gene have been associated with primary congenital glaucoma; therefore it is thought that the enzyme also metabolizes a signaling molecule involved in eye development, possibly a steroid. |
|
Applications: |
ELISA, IHC |
|
Name of antibody: |
CYP1B1 |
|
Immunogen: |
Fusion protein of human CYP1B1 |
|
Full name: |
cytochrome P450, family 1, subfamily B, polypeptide 1 |
|
Synonyms: |
CP1B; GLC3A; CYPIB1; P4501B1 |
|
SwissProt: |
Q16678 |
|
ELISA Recommended dilution: |
2000-5000 |
|
IHC positive control: |
Human thyroid cancer and human liver cancer |
|
IHC Recommend dilution: |
25-100 |
購(gòu)物車
購(gòu)物車 幫助
幫助
 021-54845833/15800441009
021-54845833/15800441009
